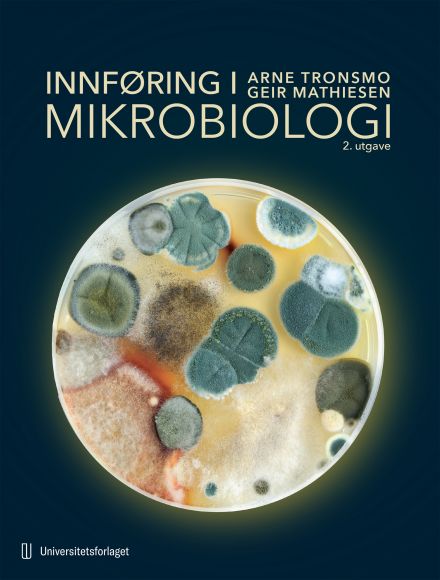

Innføring i mikrobiologi
Mikrobiologi er fagområdet som dykker ned i studiet av livsformene vi trenger mikroskop for å se: bakterier, arker, virus, sopp og protister. De finnes overalt, i et mangfold av former og i astronomiske mengder. De kan leve under ekstreme forhold i varme kilder, i radioaktive områder, eller inni og utenpå mennesker. I denne læreboken får du en bred og engasjerende innføring i dette fascinerende fagfeltet.
Boken går grundig inn på tema som den prokaryote og eukaryote celletypen, klassifisering og kjennetegn ved ulike grupper av mikroorganismer. Den dekker også emner som metabolisme, vekstbetingelser, bekjempelse av mikroorganismer, mikrobiell genetikk og metoder som benyttes i mikrobiologisk forskning. Du får også en introduksjon til anvendt, industriell og medisinsk mikrobiologi.
Andreutgaven er gjennomgående oppdatert med ny kunnskap. Særlig har kapitlene om virus og molekylærbiologiske metoder fått betydelige tillegg, med utfyllende beskrivelser SARS-CoV-2-viruset og CRISPR/Cas-metoden.
Boken er skrevet for bachelorstudenter i mikrobiologi, lærere som trenger bakgrunnskunnskap og for den som ønsker å lære mer om mikrobiologiens forunderlige verden. Den krever ingen forkunnskaper, og du får en kort og enkel innføring i relevante emner som mikrobiologien består av.
Boken går grundig inn på tema som den prokaryote og eukaryote celletypen, klassifisering og kjennetegn ved ulike grupper av mikroorganismer. Den dekker også emner som metabolisme, vekstbetingelser, bekjempelse av mikroorganismer, mikrobiell genetikk og metoder som benyttes i mikrobiologisk forskning. Du får også en introduksjon til anvendt, industriell og medisinsk mikrobiologi.
Andreutgaven er gjennomgående oppdatert med ny kunnskap. Særlig har kapitlene om virus og molekylærbiologiske metoder fått betydelige tillegg, med utfyllende beskrivelser SARS-CoV-2-viruset og CRISPR/Cas-metoden.
Boken er skrevet for bachelorstudenter i mikrobiologi, lærere som trenger bakgrunnskunnskap og for den som ønsker å lære mer om mikrobiologiens forunderlige verden. Den krever ingen forkunnskaper, og du får en kort og enkel innføring i relevante emner som mikrobiologien består av.
Informasjon om boka
- Sider: 400
- Språk: Bokmål
- ISBN: 9788215068800
- Utgivelsesdato: 05.02.2024
- Bokgruppe: 219